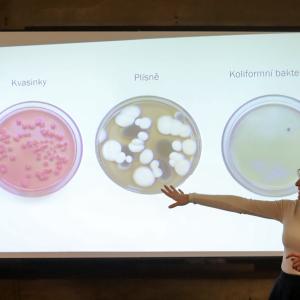
2234.jpg

Žáci oborů Analýza potravin a Praktická sestra prezentovali v Muzeu Vysočina
11. února se sešli naši žáci s pracovnicemi Muzea Vysočina Jihlava, aby si společně připomněli Mezinárodní den žen a dívek ve vědě. V příjemném prostředí Malovaného sálu muzea tak měli zúčastnění možnost zhlédnout šest zajímavých prezentací. Úvodem Aleš Karel a Amélie Berounská seznámili přítomné s životem Angeliny Hesse, jejíž objev – použití agaru jako živného média, úzce souvisí s oborem Analýza potravin, který Aleš a Amélie studují. Následně vystoupili žáci stejného oboru – Jakub Jelínek a Kristýna Karásková, aby prostřednictvím současné vědkyně Kateřiny Sam „zavedli obecenstvo do pralesa“ a poradili, jak v něm přežít. V dalším žákovském příspěvku Šárka Landsmanová představila posluchačům „Dámu s lampou“ - ošetřovatelku Florence. Šárka studuje obor Praktická sestra a Florance je jejím velkým profesním vzorem. Po krátké diskuzi vystoupil ředitel školy Libor Fasora s poutavým výkladem o významu Marie Montessori pro současné školství. Inspirativní atmosféru středečního dopoledne podtrhla ukázka projektu Plasty v našich rukách, za kterým stojí tři dívky naší školy – Aneta Říhová, Anna Švehlová a Nela Němcová. „Třešničkou na dortu“ pak bylo setkání s opravdovou vědkyní – myrmekoložkou Klárou Bezděčkovou. Pokud i vy tápete, co stojí za záhadnou profesí „myrmekoložka“, přijďte si 17. 2. poslechnout vyprávění jejího manžela https://mvji.cz/akce/science-cafe-jihlava-3x-o-mravencich. A jak odkaz napovídá, povídání bude
o jedné čeledi hmyzu…